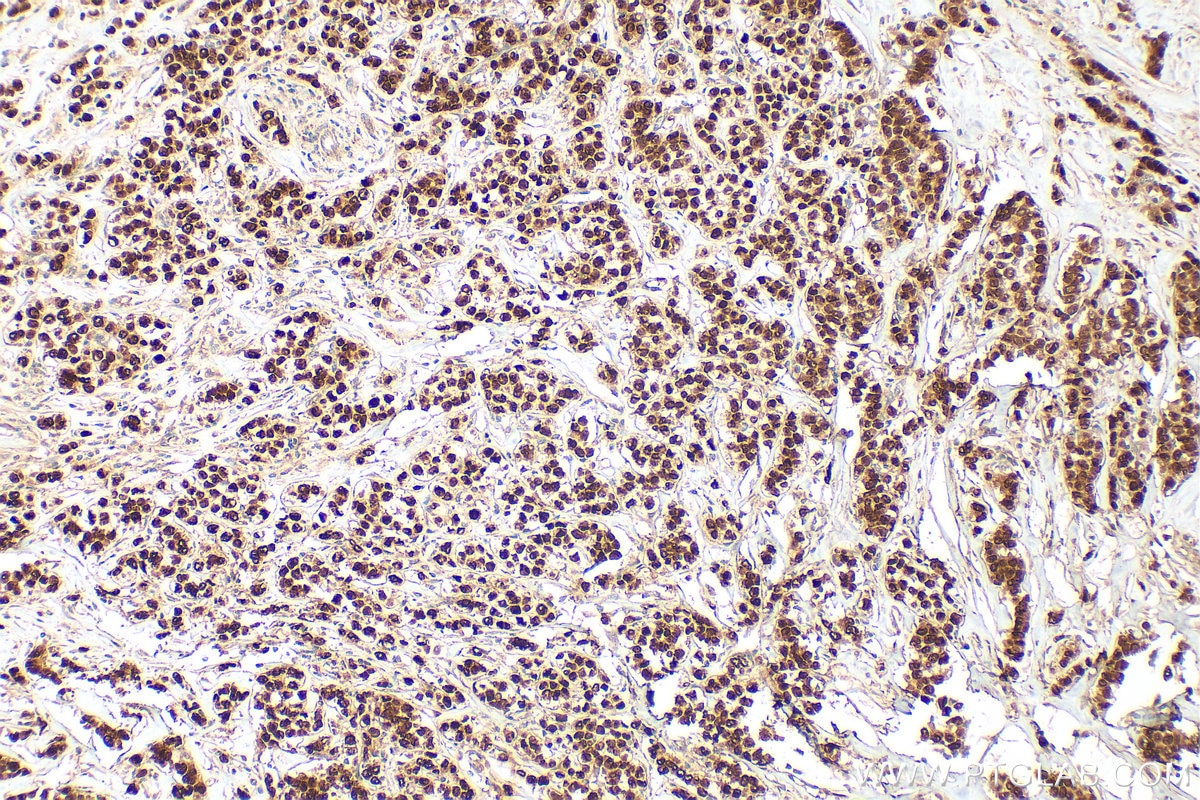
Immunohistochemistry (IHC) staining of human breast cancer tissue using Progesterone Receptor Polyclonal antibody (25871-1-AP)
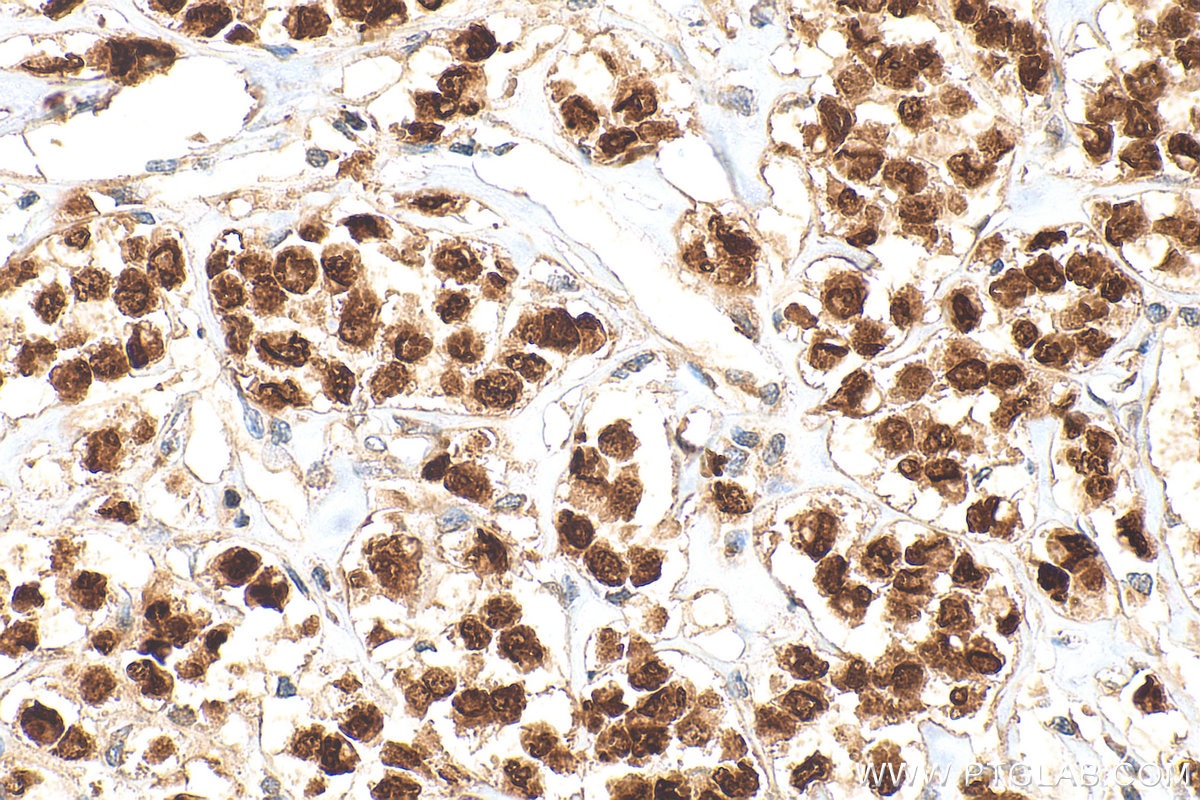
Immunohistochemistry (IHC) staining of human breast cancer tissue using Progesterone Receptor Polyclonal antibody (25871-1-AP)

Tested Applications
| Positive WB detected in | T-47D cells |
| Positive IHC detected in | human breast cancer tissue, human ovary tumor tissue Note: suggested antigen retrieval with TE buffer pH 9.0; (*) Alternatively, antigen retrieval may be performed with citrate buffer pH 6.0 |
| Positive IF-P detected in | human breast cancer tissue |
| Positive IF/ICC detected in | T-47D cells |
Recommended dilution
| Application | Dilution |
|---|---|
| Western Blot (WB) | WB : 1:5000-1:50000 |
| Immunohistochemistry (IHC) | IHC : 1:200-1:800 |
| Immunofluorescence (IF)-P | IF-P : 1:250-1:1000 |
| Immunofluorescence (IF)/ICC | IF/ICC : 1:50-1:500 |
| It is recommended that this reagent should be titrated in each testing system to obtain optimal results. | |
| Sample-dependent, Check data in validation data gallery. | |
Published Applications
| WB | See 9 publications below |
| IHC | See 22 publications below |
| IF | See 4 publications below |
Product Information
25871-1-AP targets Progesterone Receptor in WB, IHC, IF/ICC, IF-P, ELISA applications and shows reactivity with human, mouse samples.
| Tested Reactivity | human, mouse |
| Cited Reactivity | human, mouse, rat, pig, goat |
| Host / Isotype | Rabbit / IgG |
| Class | Polyclonal |
| Type | Antibody |
| Immunogen |
CatNo: Ag22986 Product name: Recombinant human PR protein Source: e coli.-derived, PGEX-4T Tag: GST Domain: 1-301 aa of NM_000926 Sequence: MTELKAKGPRAPHVAGGPPSPEVGSPLLCRPAAGPFPGSQTSDTLPEVSAIPISLDGLLFPRPCQGQDPSDEKTQDQQSLSDVEGAYSRAEATRGAGGSSSSPPEKDSGLLDSVLDTLLAPSGPGQSQPSPPACEVTSSWCLFGPELPEDPPAAPATQRVLSPLMSRSGCKVGDSSGTAAAHKVLPRGLSPARQLLLPASESPHWSGAPVKPSPQAAAVEVEEEDGSESEESAGPLLKGKPRALGGAAAGGGAAAVPPGAAAGGVALVPKEDSRFSAPRVALVEQDAPMAPGRSPLATTVM Predict reactive species |
| Full Name | progesterone receptor |
| Calculated Molecular Weight | 933 aa, 99 kDa |
| Observed Molecular Weight | 80 kDa, 110-115 kDa |
| GenBank Accession Number | NM_000926 |
| Gene Symbol | Progesterone Receptor |
| Gene ID (NCBI) | 5241 |
| RRID | AB_2880277 |
| Conjugate | Unconjugated |
| Form | Liquid |
| Purification Method | Antigen affinity purification |
| UNIPROT ID | P06401 |
| Storage Buffer | PBS with 0.02% sodium azide and 50% glycerol, pH 7.3. |
| Storage Conditions | Store at -20°C. Stable for one year after shipment. Aliquoting is unnecessary for -20oC storage. 20ul sizes contain 0.1% BSA. |
Background Information
PGR (Progesterone Receptor), also named as NR3C3 and PR, belongs to the nuclear hormone receptor family and NR3 subfamily. The steroid hormones and their receptors are involved in the regulation of eukaryotic gene expression and affect cellular proliferation and differentiation in target tissues. Progesterone receptor isoform B (PRB) is involved activation of c-SRC/MAPK signaling on hormone stimulation. The ER and PR status has been used as a predictor of breast carcinoma responsiveness to endocrine therapy and as a prognostic indicator for early recurrence. This antibody recognizes both PR-A and PR-B.
Protocols
| Product Specific Protocols | |
|---|---|
| IF protocol for Progesterone Receptor antibody 25871-1-AP | Download protocol |
| IHC protocol for Progesterone Receptor antibody 25871-1-AP | Download protocol |
| WB protocol for Progesterone Receptor antibody 25871-1-AP | Download protocol |
| Standard Protocols | |
|---|---|
| Click here to view our Standard Protocols |
Publications
| Species | Application | Title |
|---|---|---|
Nat Commun Glucocorticoid receptor regulates PD-L1 and MHC-I in pancreatic cancer cells to promote immune evasion and immunotherapy resistance. | ||
Nucleic Acids Res ZNF598 co-translationally titrates poly(GR) protein implicated in the pathogenesis of C9ORF72-associated ALS/FTD | ||
Acta Neuropathol Increased prevalence of granulovacuolar degeneration in C9orf72 mutation. | ||
J Anim Sci Biotechnol Dietary supplementation with N-acetyl-L-cysteine ameliorates hyperactivated ERK signaling in the endometrium that is linked to poor pregnancy outcomes following ovarian stimulation in pigs | ||
Int J Mol Sci The High Level of RANKL Improves IκB/p65/Cyclin D1 Expression and Decreases p-Stat5 Expression in Firm Udder of Dairy Goats | ||
Front Endocrinol (Lausanne) Effect of acupuncture on the opening time of implantation window and endometrial receptivity in controlled ovarian hyperstimulation rats during peri-implantation period |